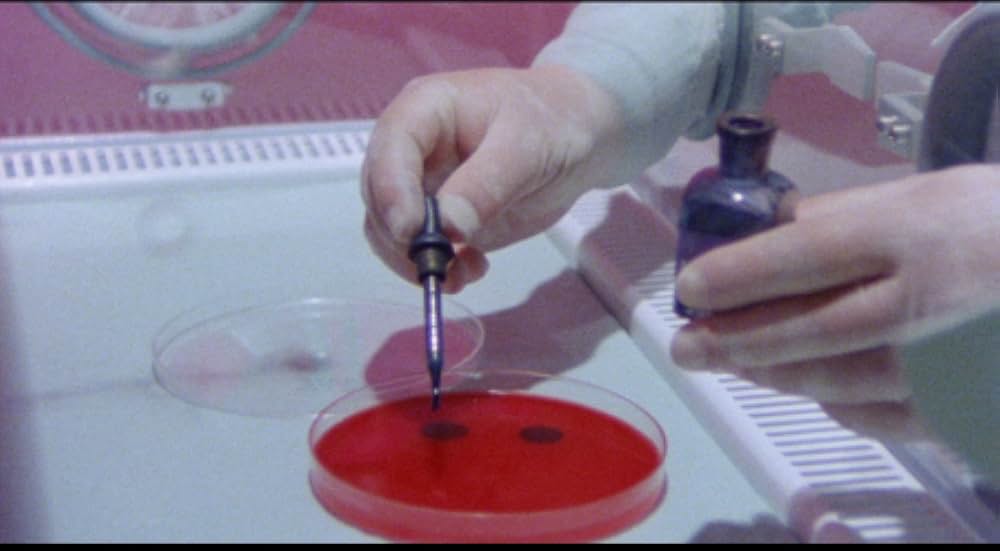
アルファ・インシデントの画像

↓↓みんなが読んでいる人気記事↓↓
→【2024年】動画配信サービスおすすめランキングに注意!人気を無料や利用者数、売上で比較!徹底版

あなたの評価は?


Idaho Transfer(原題)

ザ・コールド 人肉嗜食者達の晩餐/ザ・ゲーム 殺意のリゾートホテル

韓国の丘

死霊のはらわた 最・終・章

妖精たちの森

狂気のいけにえ

SF地底からの侵略/無差別襲撃!戦慄の殺人有機ガス

変態殺人犯!!鉄ノ爪野郎

雪男と少年

The Witch Who Came from the Sea(原題)

Tammy and the T-Rex(原題)

ドライブイン殺人事件